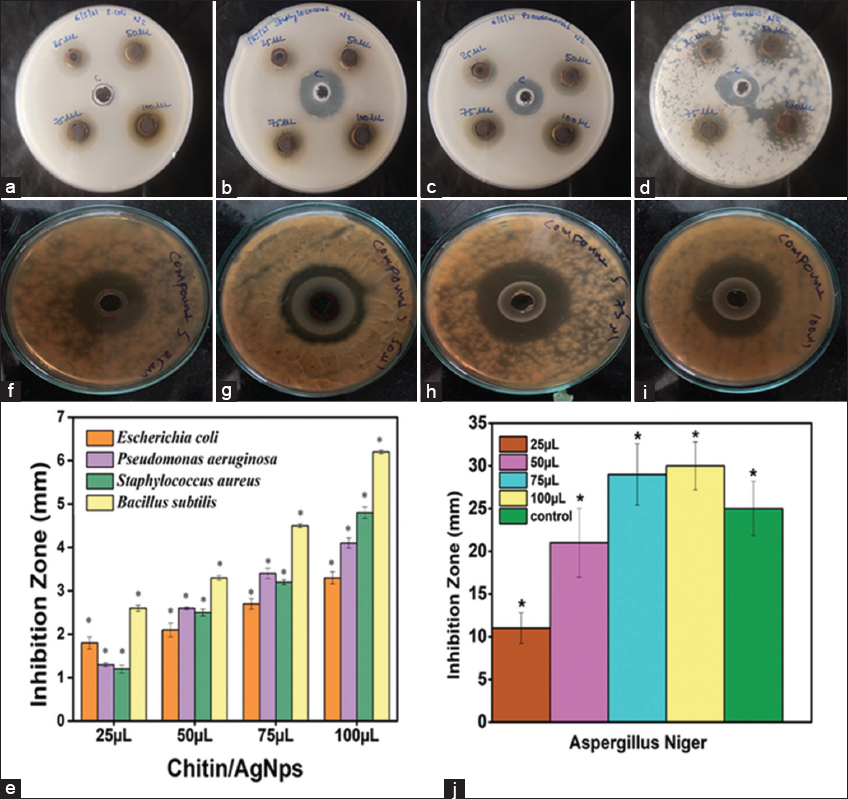

1. INTRODUCTION
Silver’s antimicrobial properties have been recognized for a long time, dating back to the era of Hippocrates (460 BC) who wrote about its role in wound healing. In the Phoenician kingdom, silver vessels were employed for water purification, further highlighting its beneficial properties [1-3]. Over the years, metallic silver, silver nitrate, and silver sulfadiazine have been employed in the treatment of wounds, burns, and various infections. Silver was particularly prevalent in wound healing during the early to mid-twentieth century. However, the advent of potent antibiotics like penicillin led to a decline in the use of silver and other non-antibiotic therapies. The emergence of antibiotic-resistant bacteria has renewed interest in alternative solutions such as silver [4]. Among various materials, nanoscale metallic particles have gained prominence. Silver nanoparticles (AgNPs), in particular, have shown remarkable effectiveness as antimicrobial agents due to their high surface area-to-volume ratio [5]. Several methods, including physical, chemical, and physicochemical processes, can be employed to produce AgNPs [6,7]. However, the physical method, although fast and requiring fewer chemicals, has drawbacks such as high energy consumption, expensive equipment, low yields, and the production of highly polydisperse samples [8,9].
To utilize the chemical method for synthesizing AgNPs, certain components are necessary. This includes a precursor metal serving as a reduction agent and as a stabilizing or capping agent [10,11]. Various reducing agents such as citrate, ascorbate, sodium borohydride, dimethylformamide, and polyol process, along with capping agents such as poly(methyl methacrylate), poly(ethylene glycol), poly(methacrylic acid), poly(vinyl alcohol), and poly(vinylpyrrolidone) are commonly employed in chemical synthesis [10,12]. However, using chemical compounds in nanoparticle synthesis poses challenges as they tend to bind to the nanoparticle surface, making it difficult to achieve high-purity nanoparticles. Therefore, there is a need for cost-effective and environmentally friendly methods to synthesize AgNPs, avoiding the use of hazardous chemicals and solvents for various biomedical applications [13,14]. Green chemical routes using extracts from natural resources such as mango, grape, pomegranate, pineapple, ginger, imperial crown leaves, moringa oleifera (drumstick tree), and citrus macroptera (wild orange), as well as chitin and chitosan, have shown promise in serving as both reducing and stabilizing agents, as evident from the literature [15-19].
Globally, approximately 6–8 million tons of waste lobster, crab, and shrimp shells are generated yearly, with Southeast Asia alone producing around 1.5 million tons of shell waste. In many developing countries, these waste shells are typically discarded in the sea or landfills [20]. However, in developed countries such as Australia, waste disposal can be costly, amounting to approximately $150 per ton [20]. Unfortunately, the potential value of such waste shells in the chemical sector has been overlooked. Scientists and industries are now focusing on finding sustainable ways to utilize crustacean shells. Chitin, a biologically compatible and biodegradable polymer, is extracted from these shells [21]. After deproteination, demineralization, and decoloration processes, chitosan is obtained from chitin, which is more biocompatible and biodegradable [22,23]. Chitin one of the most abundant biopolymers in nature after cellulose finds applications in various fields such as biocatalysts, biomedicine, the food industry, agriculture, and the pharmaceutical industry [24]. Its solubility in aqueous acid solutions and the ease with which it can be processed into different forms such as nanoparticles, microparticle films, sponges, hydrogels, and threads make chitin a versatile material [25-27]. Due to its biodegradability, biocompatibility, and wound-healing properties, chitin holds special significance in the pharmaceutical industry [21,28-30]. This study focused on synthesizing chitin-AgNPs using chitin derived from crustacean waste (shrimp shells) through a green synthetic methodology. The chitin-AgNPs were synthesized using a simple photoirradiation method without heat treatment or harsh conditions. The synthesized chitin-AgNPs were extensively characterized using various analytical techniques and their antimicrobial activities, specifically antibacterial (Gram-positive Bacillus subtilis, Staphylococcus aureus and Gram-negative Pseudomonas aeruginosa, Escherichia coli) and antifungal (Aspergillus niger) activities, were investigated.
2. MATERIALS AND METHODS
2.1. Chemicals
Silver nitrate (AgNO3), potato dextrose agar, Mueller-Hinton broth (MHB), ciprofloxacin, and fluconazole (FLC) were obtained from Sisco research laboratories, India. Phosphoric acid and sulfuric acid were purchased from Hychem Laboratories, India. DCFH-DA (2’,7’-dichlorofluorescein diacetate, 35845–5G) was obtained from Sigma Aldrich, India. The Live/dead Bac Light bacterial viability kit (L7012) was procured from Invitrogen, Korea. All the chemicals and reagents used were of analytical reagent grade and used as received without any additional purification. Deionized water (DI) was used for the preparation of all experimental solutions.
2.2. Extraction of Chitin from Shells
Shrimp shells were obtained from the local market near GITAM University, India. The collected shells were thoroughly washed with deionized (DI) water. After washing, the shells were air-dried overnight and then ground using a mortar and pestle. The resulting powder was weighed to approximately 2 g and mixed with 100 mL of 3% v/v phosphoric acid. The mixture was stirred on a magnetic stirrer at room temperature (RT) for 12 h to facilitate demineralization. The chitin extract was separated from the solid residue by filtration using Whatman No.1 filter paper. The filtrate was further subjected to centrifugation at 4000 rpm for 20 min. The supernatant, containing the chitin extract, was collected and stored at 4°C for future use.
2.3. Synthesis of Chitin-AgNPs
An initial preparation of AgNO3 solution (0.1 mM) was made and added to the chitin extract in a volume ratio 1:2 (AgNO3: chitin extract). The resulting solution was placed in a closed chamber on a magnetic stirrer and exposed to light from a 60 W incandescent bulb (Philips) at RT for 120 min. This setup allowed for the production of chitin-AgNPs. The color of the solution changed from colorless to brown, indicating the formation of chitin-AgNPs through the reduction of silver ions. The synthesized chitin-AgNPs were then stored at 4°C to further analysis and investigation of their potential biomedical applications.
2.4. Characterization Techniques
The optical properties of chitin-AgNPs were investigated using a UV–visible spectrophotometer (UV 1800, Shimadzu, Japan). Fourier-transform infrared analysis (FT-IR) to examine the functional groups of chitin-AgNPs was conducted using a Bruker ATR-FTIR spectrometer in ATR mode (USA). Transmission electron microscopy (TEM) was performed using a JEOL-2100F microscope (USA) operating at 200 kV for size determination analysis of particles. The chitin-AgNP solution was deposited onto carbon-coated copper grids for TEM imaging. Fluorescent images of chitin-AgNPs were captured using a Nikon Invitrogen fluorescence microscope (Eclipse 80i, Japan). Image analysis of chitin-AgNPs was conducted using Origin 9 and Image J software [31,32]. All experiments were performed in triplicates to ensure the reliability and reproducibility of the results.
2.5. Antibacterial Activity
The agar-well diffusion method [33] was employed to evaluate the antibacterial properties of the chitin-AgNPs against various bacterial strains, including S. aureus (ATCC 6538 KCCP 60034), B. subtilis (ATCC 23875) Gram-positive, E. coli (C600), and P. aeruginosa (ATCC 15442) Gram-negative are obtained from Korean Culture Collection of Probiotics KCCP (50037). Ciprofloxacin (1 mg/mL, antibiotic) was used as a positive reference. The bacterial strains were cultured in sterilized MHB and incubated at 37°C for 18 h. The MHB medium containing bacterial inoculums was aseptically transferred to Petri plates. Prepared wells with a diameter of 8 mm received additions of 25, 50, 75, and 100 μL (1 mg/mL) of chitin-AgNPs corresponding to the respective wells. Wells with a diameter of 8 mm were prepared, and 25, 50, 75, and 100 μL (1 mg/mL) of chitin-AgNPs were added to the respective wells. The plates were then incubated at 37°C overnight. After incubation, the diameter of the inhibition zone formed around each well was measured in millimeters to assess the antibacterial activity. To ensure the reliability and reproducibility of the results, all experiments were performed in triplicates.
2.6. Antifungal Activity
The agar-well diffusion method was employed to evaluate the antifungal properties of the chitin-AgNPs against A. niger (ATCC 11414) are obtained from Korean Culture Collection of Probiotics KCCP (50037). As a positive reference, FLC, an antifungal agent, was used at a concentration of 1 mg/mL. Potato dextrose agar slants were prepared and incubated at 37°C for 24 h to investigate the antifungal activity. The prepared medium was then poured into Petri plates and allowed to solidify under aseptic conditions. A sterile cotton swab was dipped into the fungal strain suspension and used to inoculate the agar surface. The inoculum was spread evenly across the entire agar surface by streaking in three directions with the cotton swab. Prepared wells with a diameter of 8 mm received additions of 25, 50, 75, and 100 μL (1 mg/mL) of chitin-AgNPs corresponding to the respective wells. The plates were incubated at 37°C for 4 days. After incubation, the diameter of the inhibitory zones formed around each well was measured in millimeters to evaluate the antifungal activity. These experiments were conducted in triplicates to ensure reliable results.
2.7. Live/Dead Cell Viability Assay
Bacterial cell viability of E. coli and B. subtilis was assessed using a live and dead staining assay after treatment with chitin-AgNPs. The bacterial cells were incubated for 60 min following treatment with a live and dead cell staining solution. Subsequently, the untreated and treated cells of E. coli and B. subtilis, along with the control, were examined using a fluorescence microscope. Images were captured using Nikon’s live cell capture software.
2.8. Reactive Oxygen Species (ROS) Assay
DCFH-DA (2′,7′-dichlorodihydrofluorescein diacetate) was employed to assess the production of ROS in E. coli and B. subtilis following treatment with chitin-AgNPs (25, 50, 75, and 100 μL). The excitation and emission wavelengths used were 480 nm and 520 nm, respectively. Sixteen-well plates were used, and incremental amounts of chitin-AgNPs (25, 50, 75, and 100 μL) were added to each well. The plates were then incubated separately with 1 mL of E. coli and B. subtilis for 6 h at 37°C. The bacterial suspension was incubated in the dark for 30 min after adding 100 M DCFH-DA. Subsequently, 10 μL of each aliquot was placed on a glass slide, covered with a cover slip, and studied using a fluorescence microscope with a ×100 objective lens and a green filter.
2.9. Statistical Analysis
All the complete data shown in this research work were the mean and standard deviation (±SD) of three individual experiments. Three-factor analysis of variance, ANOVA, was performed, and the statistical significance between values was accepted. The values were presented as the mean.
3. RESULTS AND DISCUSSION
In this work, chitin was obtained from crustacean wastes by a green synthetic approach. Later, the obtained bio-based eco-friendly chitin biopolymer was used as stabilizing and reducing agent for the preparation of AgNPs by photoirradiation reaction as shown in Figure 1. The prepared chitin/AgNPs were thoroughly investigated using TEM, FT-IR, and ultraviolet-visible absorption spectroscopy. Further, chitin-AgNPs were used to study the antifungal and antibacterial effect against various microorganisms and compared with reference materials.
 | Figure 1: Schematic illustration for the synthesis of the chitin-AgNPs. [Click here to view] |
3.1. Optical Properties
The brown color of chitin-AgNPs results from the surface plasmon resonance phenomenon surface plasmon resonance (SPR), which occurs due to the collective oscillation of electrons on the metal surface. This phenomenon is characterized by a distinct absorption band in the 400–500 nm range. The absorption spectra of chitin-AgNPs exhibit a broad absorption band at 450–480 nm [Figure 2a and b], which indicates SPR. The broadening of the band suggests the presence of polydispersity in the chitin-AgNPs. The optimal ratio of AgNO3 to chitin was observed as 1:2 v/v from Figure 2a. Then, the 1:2 v/v mixture of AgNO3 and chitin solution was exposed to photo-irradiation for different time interval. The optimal formation of chitin-AgNPs was observed when a mixture of AgNO3 and chitin solution subjected to photoirradiation for 120 min.
 | Figure 2: UV-visible absorption spectra of chitin-AgNPs (a) at different amounts of chitin and (b) at different reaction times. [Click here to view] |
3.2. FT-IR Studies
The FT-IR analysis was conducted to investigate the chemical functionalities of the synthesized chitin-AgNPs [Figure 3]. The FT-IR spectra of chitin-AgNPs exhibit prominent peaks at 3457, 1640, 1182, 1006, and 660 cm-1. The peak at 3457 cm-1 corresponds to the stretching vibrations of alcohol (-OH) groups, while the peak at 1640 cm-1 is attributed to the amide I band. The peaks at 1182, 1006, and 660 cm-1 can be attributed to the stretching vibrations of the (C-O) bonds in the saccharide structure of chitin. In addition, peaks at 2884, 2963, and 1393 cm-1 are observed, which corresponds to the symmetric stretching of -CH2 groups, the asymmetric stretching of -CH2 groups, and -CH bending vibrations, respectively [34]. These results confirm the successful modification of chitin with the newly formed chitin-AgNPs.
 | Figure 3: FT-IR spectra of (a) chitin and (b) chitin-AgNPs. [Click here to view] |
3.3. Morphological Studies
The morphology and dispersion ability of the synthesized chitin-AgNPs were examined using low-resolution TEM and HRTEM analysis [Figure 4]. The TEM images of the as-prepared chitin-AgNPs revealed a spherical morphology with uniform dispersion [Figure 4a-e]. By analyzing the TEM images using Image J software, the average particle size of chitin-AgNPs was determined to be in the range of 10–30 nm. The particle size distribution of the chitin-AgNPs, depicted in the histogram [Figure 4f], was calculated using Origin software (Gaussian distribution).
 | Figure 4: (a-c) Low-resolution transmission electron microscopy (TEM) and (d and e) HRTEM images of chitin-AgNPs, and (f) particle size distribution curve of the chitin-AgNPs. [Click here to view] |
3.4. Antibacterial Activity of Chitin-AgNPs
The antibacterial effect of chitin-AgNPs was evaluated using the well-diffusion method against Gram-positive bacteria S. aureus and B. subtilis, as well as Gram-negative bacteria E. coli and P. aeruginosa [Figure 5a-e]. The results showed that chitin-AgNPs exhibited the highest zone of inhibition against B. subtilis (6.2 mm) compared to E. coli (3.3 mm) when added at a concentration of 100 μL. The zone of inhibition increased incrementally with the addition of chitin-AgNPs (25, 50, 75, and 100 μL), with the highest inhibition observed at 100 μL. The antibacterial activity of chitin-AgNPs at 100 μL was comparable to that of ciprofloxacin (1 mg/mL), a well-known antibacterial agent, for most of the strains tested, and it performed better than the control in the case of B. subtilis [Table 1]. The observed antibacterial activity of chitin-AgNPs is consistent with previous studies where AgNPs demonstrated size-dependent toxicity on microbial species, with smaller nanoparticles showing decreased toxicity [35]. The size of chitin-AgNPs ranges from 10 to 30 nm, indicating their effectiveness in exerting bactericidal and fungicidal effects on various microbial species, even at low concentrations. In a related study, Xinjing Wei et al. [36] reported the antibacterial effect of AgNPs prepared using a green approach against E. coli and S. aureus. This work builds upon using chitin extracted from shrimp shell waste to achieve antibacterial effects against four different bacterial strains. The generation of ROS within bacterial cells can be attributed to the observed antibacterial activity of chitin-AgNPs. The rigid plasma membrane of Gram-positive bacteria is more susceptible to membrane damage, while the flexible membrane of Gram-negative bacteria allows for external damage. However, the synthesized chitin-AgNPs demonstrated similar effects on both species under comparable conditions.
| Figure 5: The antibacterial and antifungal effect of chitin-AgNPs. The images of inhibition zones (a) Escherichia coli, (b) Staphylococcus aureus, (c) Pseudomonas aeruginosa, (d) B. subtilis, and (e, f, g, and h) Aspergillus niger at incremental concentrations (25, 50, 75, and 100 μL), and (i and j) histogram profiles for the zone of inhibition for antibacterial and antifungal activities. SD (Standard deviation) bars derived from the mean of data from three individual experiments with * indicates P < 0.01 [Click here to view] |
Table 1: Antibacterial and antifungal activities for the chitin-AgNPs.
| Chitin-AgNPsa | DIZ in mm | ||||
|---|---|---|---|---|---|
| 25 μL | 50 μL | 75 μL | 100 μL | Control* (Ciprofloxacin/fluconazole) | |
| E. coli | 1.8±0.14 | 2.1±0.16 | 2.7±0.12 | 3.3±0.14 | 4.1±0.16 |
| P. aeruginosa | 1.3±0.04 | 2.6±0.03 | 3.4±0.12 | 4.1±0.12 | 5.0±0.12 |
| S. aureus | 1.2±0.09 | 2.5±0.08 | 3.2±0.06 | 4.8±0.13 | 5.4±0.12 |
| B. subtilis | 2.6±0.07 | 3.3±0.05 | 4.5±0.04 | 6.2±0.04 | 6.0±0.04 |
| A. niger | 19±1.8 | 21±4.0 | 29±3.6 | 30±2.8 | 25±3.2 |
*Ciprofloxacin for bacterial strains and fluconazole for fungal strain were used as controls. ±SD values of this research work derived from the mean of data from three individual experiments, S. aureus: Staphylococcus aureus, P. aeruginosa: Pseudomonas aeruginosa, A. niger: Aspergillus niger, DIZ: Diameter of inhibition zone.
3.5. Antifungal Activity of Chitin-AgNPs
The antifungal activities of chitin-AgNPs were analyzed by well-diffusion method using chitin-AgNPs against A. niger and presented in Figure 5f-j. Similar to the antibacterial effect, chitin-AgNPs have shown an incremental increase in the zone of inhibition under incremental addition (25, 50, 75, and 100 μL) of chitin-AgNPs with the highest inhibition at 100 μL. Antifungal activity of chitin-AgNPs (100 μL) was found to have an inhibition region of ~30 mm which performed better than the well-known antifungal agent, FLC (1 mg/mL), which has an inhibition region of ~25 mm [Table 1]. The antibacterial and antifungal activities of chitin-AgNPs increased as the amount of AgNPs in the chitin matrix.
3.6. Live/Dead Cell Viability Assay
The capability of chitin-AgNPs on E. coli and B. subtilis cells has been examined using the live and dead assay to observe the membrane damage in these cell lines. In this study, for differentiation in the color green and red the E. coli and B. subtilis cells were stained by SYTO 9 and propidium iodide, respectively. The appearance of green color fluorescence in the cells confirms that the intact membrane was making them alive, and the formation of red color fluorescence denotes a damaged cell membrane vis a vis dead cell. E. coli cells (control) display a characteristic intact morphology with intense green fluorescence [Figure 6a]. The chitin-AgNPs treated E. coli cells with incremental addition (25, 50, 75, and 100 μL) display a decrease in the number of green fluorescent cells and an increase in the cells with red fluorescence [Figure 6b-e]. Similarly, the B. subtilis (control) exhibits a distinctive intact morphology with intense green fluorescence [Figure 6f]. The chitin-AgNPs treated B. subtilis with incremental addition (25, 50, 75, and 100 μL) displays a decrease in the number of green fluorescent cells and there is an increase in the cells with red fluorescence [Figure 6g-j]. This effectively confirms that the synthesized chitin-AgNPs have a significant bactericidal effect on both E. coli and B. subtilis, showing excellent antimicrobial efficiency.
 | Figure 6: Live and dead cells staining assay images (a) Escherichia coli cells (untreated: control), (b-e) after treatment with chitin-AgNPs (25, 50, 75, and 100 μL), (f) B. subtilis cells (untreated: control), and (g-j) after treatment with chitin-AgNPs (25, 50, 75, and 100 μL) (Conditions: lens; objective, dyes: SYTO 9 (for green color) and propidium iodide (for red color), dye concentrations: followed according to the protocol). [Click here to view] |
3.7. ROS Assay
The main reason for cell damage in antibacterial activity is oxidative stress created by chitin/AgNPs. The ROS assay studies were performed on E. coli and B. subtilis by treating them with incremental addition of chitin-AgNPs (25, 50, 75, and 100 μL) incubation for 6 h and stained with DCFH-DA (2′,7′-dichlorofluorescein diacetate) for the determination of oxidative stress facilitated by chitin/AgNPs. As the amount of addition of chitin-AgNPs is increased, a significant increase in oxidative stress was noticed in both E. coli and B. subtilis, which is evident from the increase in green fluorescence [Figure 7, Supporting Information Table S1, Figures S1 and S2]. Compared with untreated cells, cells treated with chitin-AgNPs showed an increase in ROS production, leading to cell death in both bacterial strains. To discuss the antibacterial activity of chitin/AgNPs, the possible mechanism of action has been explored through ROS assay, as shown in Figure 8 (Figure was drawn using “ChemBiodraw Ultra 14.0” software tool). The effective antimicrobial activity of AgNPs is owing to their capability of generating ROS and free radical species such as H2O2, O2−, OH•, HOCl, and singlet oxygen [37]. The antibacterial ability of AgNPs is correlated with ROS and free radicals’ production and subsequent rise in oxidative stress in cells [38,39]. The ROS generation in the bacterial cells may have been attributed to the degradation of bacterial cellular constituents, including DNA, lipids, and proteins. It is believed that the cellular internalization of H2O2 may have played a key role in the degradation of cellular constituents by losing the integrity of bacterial cells. Herein, the chitin-AgNPs may have induced the exposure of radicals, i.e., O2− and HO2– on the bacterial cells, which triggers the degradation of bacterial cellular constituents. A higher concentration of Ag+ ions is probable to cause a rise in cellular oxidative stress. Hence, the antibacterial activity is mainly based on the potential involvement of ROS. Increased ROS level can increase the oxidative stress in bacterial cells, which lead to effective bacterial killing [33,40,41]. The above mechanism strongly correlated with the ROS assay results [Table S1, Figures S1 and S2].
 | Figure 7: ROS assay analysis for chitin-AgNPs in B. subtilis (a) B. subtilis cells (untreated, i.e., control), and (b-e) after the treatment with chitin-AgNPs (25, 50, 75, and 100 μL), (f) Escherichia coli cells (untreated, i.e., control), (g-j) after the treatment with chitin-AgNPs (25, 50, 75, and 100 μL), [Conditions: lens; objective, dyes: 2′,7′-dichlorodihydrofluorescein diacetate (DCFH-DA), dye concentrations: followed according to the protocol]. [Click here to view] |
 | Figure 8: Schematic illustration for the antibacterial activity of chitin-AgNPs through ROS production. [Click here to view] |
Shrimp shell waste is produced in massive quantities from the shrimp processing sectors worldwide, and it is mostly disposed into landfill or the sea, resulting in extreme environmental pollution. Waste Crustacean shell is among the major resources exploited for producing protein, chitin, and calcium carbonate. Crustacean shells contain 15–40% chitin 20–50%, calcium carbonate, and 20–40% protein. Protein is used as animal feed. As livestock reproduction increases promptly, crustacean waste shells from southeast Asia may possibly be converted into rich protein animal feed with a market value of >$100 million. Calcium carbonate has widespread applications in the agricultural, pharmaceutical, paper, and construction sectors. At present, it comes from limestone and marble. The cheapest coarse particles were produced from crustacean waste shells from Asia with a market value of up to $45 million. Another important material obtained from the crustacean shell is chitin. Chitin is the 2nd highest abundant biopolymer on the globe after the cellulose biopolymer. Currently, chitin and chitosan are employed in various industrial applications, such as textile, cosmetics, biomedicine, and water treatment [20,42,43]. Recently, chitin is investigated as a natural cationic biopolymer due to its exceptional biocompatibility, non-toxicity, biodegradability, antimicrobial ability, etc. In this work, chitin was obtained from crustacean wastes by a green synthetic approach. Later, the obtained bio-based eco-friendly chitin biopolymer was used as stabilizing and reducing agent for preparation of AgNPs by photoirradiation reaction. The developed chitin/AgNPs showed good antifungal and antibacterial effect against various microorganisms. Shrimp shell waste is not only used for the production of chitin also it is used as probable raw material for the production of bioethanol and biodiesel [43]. Further shrimp shell waste used as an efficient adsorbent for removal of metal from polluted water and explored as antioxidant, and neuroprotective activities [44,45]. Still, there is lot of scope to utilize the shrimp shell waste in different fields. In future, we plan to use shrimp shell waste in diverse applications, including as a catalyst, adsorbent, hydrogel material for bioelectronics, etc.
4. CONCLUSION
In this study, we successfully synthesized chitin-AgNPs using a simple and environmentally friendly chemical approach, avoiding the use of hazardous chemicals. The chitin extract derived from crustacean shells served as an effective reducing, protecting/capping, and stabilizing agent. The UV-visible absorption studies demonstrated a distinct and intense SPR peak at 470 nm, indicating the successful formation of chitin-AgNPs. TEM analysis revealed that the synthesized chitin-AgNPs exhibited a particle size range of 10–30 nm and displayed good dispersibility and stability in water. Furthermore, the synthesized chitin-AgNPs exhibited remarkable biocidal activity against the Gram-positive bacterium B. subtilis and displayed antifungal effects against A. niger, surpassing the efficacy of commercially available drugs. These findings position chitin-AgNPs as a promising alternative in the field of antimicrobial agents. Mechanistic studies provided insights into the potential cell-killing mechanism of AgNPs in E. coli and B. subtilis. Overall, the environmentally friendly synthesis of chitin-AgNPs highlights their potential for utilization as effective antimicrobial agents in the near future.
5. ACKNOWLEDGMENTS
The authors are thankful to GITAM (Deemed to be University), Hyderabad, for providing laboratory facilities.
6. AUTHOR CONTRIBUTIONS
NKT: Investigation, Methodology, Formal analysis, Data curation, Writing–original draft. LVKK: Data curation, Investigation, Writing–original draft. RS: Investigation, Data curation, Writing–original draft, Writing-review, and editing. RG: Resources, Visualization, Supervision, Project administration, Funding acquisition, Writing-review, and editing. SD: Visualization, Resources, Supervision, Project administration, Funding acquisition, Writing-review and editing.
6. FUNDING
There is no funding to report.
7. CONFLICTS OF INTEREST
The authors report no financial or any other conflicts of interest in this work.
8. ETHICAL APPROVALS
This study does not involve experiments on animals or human subjects.
9. DATA AVAILABILITY
All the data obtained in this study are represented as table and figures in the manuscript.
10. PUBLISHER’S NOTE
This journal remains neutral with regard to jurisdictional claims in published institutional affiliation.
REFERENCES
1. Alexander JW. History of the medical use of silver. Surg Infect (Larchmt) 2009;10:289-92. [CrossRef]
2. Silver S, Phung LT. Bacterial heavy metal resistance:New surprises. Annu Rev Microbiol 1996;50:753-89. [CrossRef]
3. Yamada K. The Origins of Acupuncture, Moxibustion, and Decoction:The Two Phases of the Formation of Ancient Medicine. Kyoto, Japan:International Research Centre for Japanese Studies;1998.
4. Sim W, Barnard RT, Blaskovich MA, Ziora ZM. Antimicrobial silver in medicinal and consumer applications:A patent review of the past decade (2007-2017). Antibiotics (Basel) 2018;7:93. [CrossRef]
5. Hamad A, Khashan KS, Hadi A. Silver nanoparticles and silver ions as potential antibacterial agents. J Inorg Organomet Polym Mater 2020;30:4811-28. [CrossRef]
6. Aljohani MM, Abu-Rayyan A, Elsayed NH, Alatawi FA, Al-Anazi M, Mustafa SK, et al. One-pot microwave synthesis of chitosan-stabilized silver nanoparticles entrapped polyethylene oxide nanofibers, with their intrinsic antibacterial and antioxidant potency for wound healing. Int J Biol Macromol 2023;235:123704. [CrossRef]
7. Aranaz I, Navarro-García F, Morri M, Acosta N, Casettari L, Heras A. Evaluation of chitosan salt properties in the production of AgNPs materials with antibacterial activity. Int J Biol Macromol 2023;235:123849. [CrossRef]
8. Faried M, Shameli K, Miyake M, Zakaria Z, Hara H, Khairudin NB, et al. Ultrasound-assisted in the synthesis of silver nanoparticles using sodium alginate mediated by green method. Dig J Nanomater Biostruct 2016;11:547-52.
9. Navaladian S, Viswanathan B, Viswanath R, Varadarajan T. Thermal decomposition as route for silver nanoparticles. Nanoscale Res Lett 2007;2:44-8. [CrossRef]
10. Iravani S, Korbekandi H, Mirmohammadi SV, Zolfaghari B. Synthesis of silver nanoparticles:Chemical, physical and biological methods. Res Pharm Sci 2014;9:385-406.
11. Pryshchepa O, Pomastowski P, Buszewski B. Silver nanoparticles:Synthesis, investigation techniques, and properties. Adv Colloid Interface Sci 2020;284:102246. [CrossRef]
12. Somlyai-Sipos L, Baumli P, Sycheva A, Kaptay G, Szori-Doroghazi E, Kristaly F, et al. Development of Ag nanoparticles on the surface of Ti powders by chemical reduction method and investigation of their antibacterial properties. Appl Surf Sci 2020;533:147494. [CrossRef]
13. Phan TT, Phan DT, Cao XT, Huynh TC, Oh J. Roles of chitosan in green synthesis of metal nanoparticles for biomedical applications. Nanomaterials (Basel) 2021;11:273. [CrossRef]
14. AlNadhari S, Al-Enazi NM, Alshehrei F, Ameen F. A review on biogenic synthesis of metal nanoparticles using marine algae and its applications. Environ Res 2021;194:110672. [CrossRef]
15. Alobaid HM, Alzhrani AH, Majrashi NA, Alkhuriji AF, Alajmi RA, Yehia HM, et al. Effect of biosynthesized silver nanoparticles by Garcinia mangostana extract against human breast cancer cell line MCF-7. Food Sci Technol 2022;42:41622. [CrossRef]
16. Al-Otibi F, Alkhudhair SK, Alharbi RI, Al-Askar AA, Aljowaie RM, Al-Shehri S. The antimicrobial activities of silver nanoparticles from aqueous extract of grape seeds against pathogenic bacteria and fungi. Molecules 2021;26:6081. [CrossRef]
17. Saha P, Mahiuddin M, Islam AB, Ochiai B. Biogenic synthesis and catalytic efficacy of silver nanoparticles based on peel extracts of Citrus macroptera fruit. ACS Omega 2021;6:18260-8. [CrossRef]
18. Liu L, Seta FT, An X, Yang J, Zhang W, Dai H, et al. Facile isolation of colloidal stable chitin nano-crystals from Metapenaeus ensis shell via solid maleic acid hydrolysis and their application for synthesis of silver nanoparticles. Cellulose 2020;27:9853-75. [CrossRef]
19. Tyavambiza C, Elbagory AM, Madiehe AM, Meyer M, Meyer S. The antimicrobial and anti-inflammatory effects of silver nanoparticles synthesised from Cotyledon orbiculata aqueous extract. Nanomaterials (Basel) 2021;11:1343. [CrossRef]
20. Yan N, Chen X. Sustainability:Don't waste seafood waste. Nature 2015;524:155-7. [CrossRef]
21. Kalaivani R, Maruthupandy M, Muneeswaran T, Beevi AH, Anand M, Ramakritinan CM, et al. Synthesis of chitosan mediated silver nanoparticles (Ag NPs) for potential antimicrobial applications. Front Lab Med 2018;2:30-5. [CrossRef]
22. Crini G. Historical review on chitin and chitosan biopolymers. Environ Chem Lett 2019;17:1623-143. [CrossRef]
23. Okafor VN, Abimbola BA, Iwe AD, Mbume OF. Comparative studies of chitosan-silver nanocomposites from commercial and biowaste sources. Nanochem Res 2023;8:78-86.
24. Aranaz I, Mengibar M, Harris R, Miralles B, Acosta N, Calderon L, et al. Role of physicochemical properties of chitin and chitosan on their functionality. Curr Chem Biol 2014;8:27-42. [CrossRef]
25. Elsabee MZ, Abdou ES. Chitosan based edible films and coatings:A review. Mater Sci Eng C Mater Biol Appl 2013;33:1819-41. [CrossRef]
26. Croisier F, Jerome C. Chitosan-based biomaterials for tissue engineering. Eur Polym J 2013;49:780-92. [CrossRef]
27. Bhattarai N, Gunn J, Zhang M. Chitosan-based hydrogels for controlled, localized drug delivery. Adv Drug Deliv Rev 2010;62:83-99. [CrossRef]
28. Tiboni M, Elmowafy E, El-Derany MO, Benedetti S, Campana R, Verboni M, et al. A combination of sugar esters and chitosan to promote in vivo wound care. Int J Pharm 2022;616:121508. [CrossRef]
29. Gowda BH, Ahmed MG, Chinnam S, Paul K, Ashrafuzzaman M, Chavali M, et al. Current trends in bio-waste mediated metal/metal oxide nanoparticles for drug deliver. J Drug Deliv Sci Technol 2022;71:103305. [CrossRef]
30. Liu X, Chen JL, Yang WY, Qian YC, Pan JY, Zhu CN, et al. Biosynthesis of silver nanoparticles with antimicrobial and anticancer properties using two novel yeasts. Sci Rep 2021;11:15795. [CrossRef]
31. Schneider CA, Rasband WS, Eliceiri KW. NIH Image to ImageJ:25 years of image analysis. Nat Methods 2012;9:671-5. [CrossRef]
32. Seifert E. OriginPro 9.1:Scientific data analysis and graphing software-software review. J Chem Inf Model 2014;54:1552. [CrossRef]
33. Chakka SV, Thanjavur N, Lee S, Kim S. Synthesis and characterization of lanthanum-doped curcumin-functionalized antimicrobial copper oxide nanoparticles. J Rare Earths 2022;41:1606-15. [CrossRef]
34. Solairaj D, Rameshthangam P. Silver nanoparticle embedded a-chitin nanocomposite for enhanced antimicrobial and mosquito larvicidal activity. J Polym Environ 2017;25:435-52. [CrossRef]
35. Ivask A, Kurvet I, Kasemets K, Blinova I, Aruoja V, Suppi S, et al. Size-dependent toxicity of silver nanoparticles to bacteria, yeast, algae, crustaceans and mammalian cells in vitro. PLoS One 2014;9:e102108. [CrossRef]
36. Wei X, Cheng F, Yao Y, Yi X, Wei B, Li H, et al. Facile synthesis of a carbon dots and silver nanoparticles (CDs/AgNPs) composite for antibacterial application. RSC Adv 2021;11:18417-22. [CrossRef]
37. Kim SH, Lee HS, Ryu DS, Choi SJ, Lee DS. Antibacterial activity of silver-nanoparticles against Staphylococcus aureus and Escherichia coli. Korean J Microbiol Biotechnol 2011;39:77-85.
38. Wu D, Fan W, Kishen A, Gutmann JL, Fan B. Evaluation of the antibacterial efficacy of silver nanoparticles against Enterococcus faecalis biofilm. J Endod 2014;40:285-90. [CrossRef]
39. Dakal TC, Kumar A, Majumdar RS, Yadav V. Mechanistic basis of antimicrobial actions of silver nanoparticles. Front Microbiol 2016;7:1831. [CrossRef]
40. Mammari N, Lamouroux E, Boudier A, Duval RE. Current knowledge on the oxidative-stress-mediated antimicrobial properties of metal-based nanoparticles. Microorganisms 2022;10:437. [CrossRef]
41. Memar MY, Ghotaslou R, Samiei M, Adibkia K. Antimicrobial use of reactive oxygen therapy:Current insights. Infect Drug Resist 2018;11:567-76. [CrossRef]
42. Hu X, Tian Z, Li X, Wang S, Pei H, Sun H, et al. Green, simple, and effective process for the comprehensive utilization of shrimp shell waste. ACS Omega 2020;5:19227-35. [CrossRef]
43. Suryawanshi N, Eswari JS. Shrimp shell waste as a potential raw material for biorefinery-a revisit. Biomass Convers Biorefin 2022;12:1977-84. [CrossRef]
44. Maia ML, Grosso C, Barroso MF, Silva A, Delerue-Matos C, Domingues VF. Bioactive compounds of shrimp shell waste from Palaemon serratus and Palaemon varians from Portuguese coast. Antioxidants (Basel) 2023;12:435. [CrossRef]
45. Gok G, Kocyigit H, Gok O, Celebi H. The use of raw shrimp shells in the adsorption of highly polluted waters with Co2+. Chem Eng Res Des 2022;186:229-40. [CrossRef]